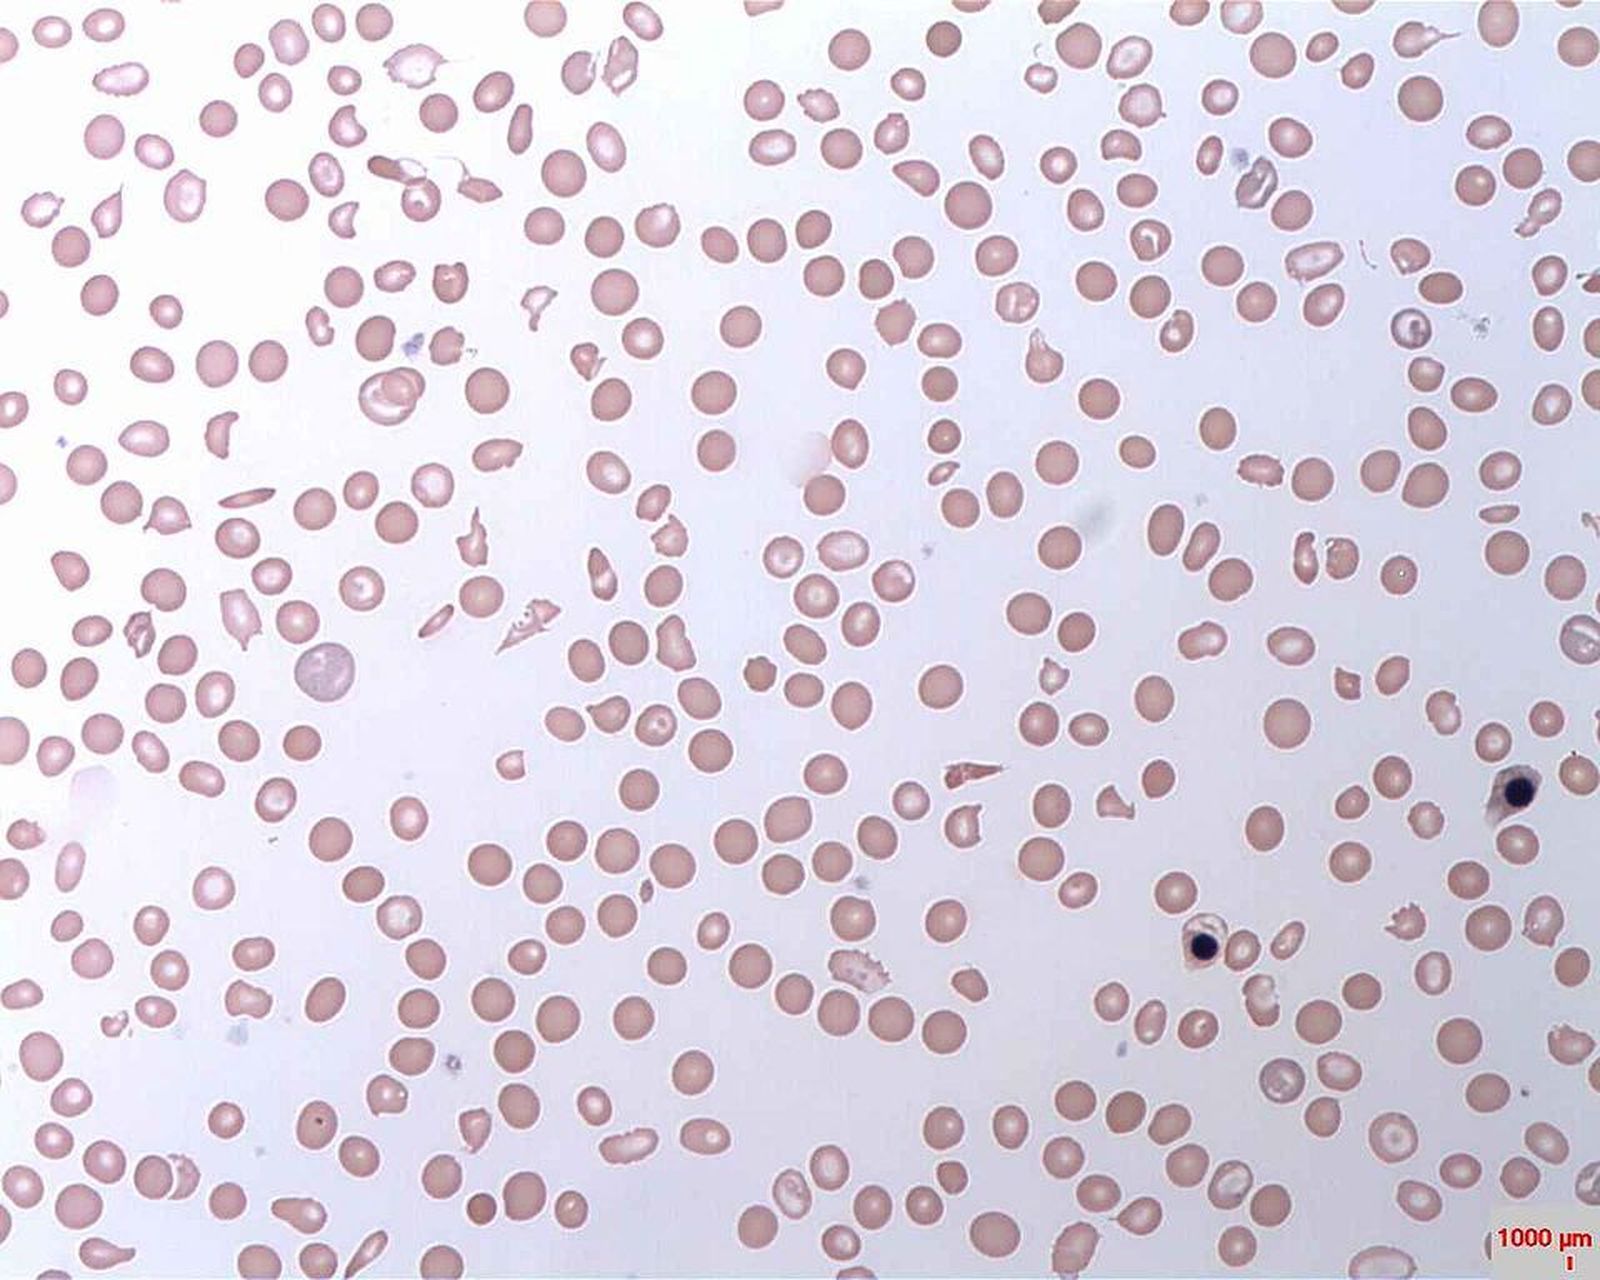
47547

El déficit de hierro impacta en la salud de las mujeres, la insuficiencia cardíaca crónica y la enfermedad renal
La Alianza Europea para la Salud del Riñón, la Red de Insuficiencia Cardíaca, la Anemia Community y Vifor Pharma instan a la sociedad a 'Tomarse el hierro en serio' en la quinta edición de este Día Mundial
Desde su creación en 2015, el 26 de noviembre, Día Mundial del Déficit de Hierro, ha tenido como objetivo formar a las personas en todo el mundo sobre la importancia del hierro para el cuerpo y el grave impacto que puede tener si sus niveles no se manejan adecuadamente, alentando a la población a estar mejor informada y tomar el control de su salud. En esta edición, la Alianza Europea para la Salud del Riñón, la Red de Insuficiencia Cardíaca, la organización internacional Anemia Community y Vifor Pharma hacen hincapié en el impacto del déficit de hierro en la salud de las mujeres, la insuficiencia cardíaca crónica y la enfermedad renal.
Se estima que el déficit de hierro y la anemia por déficit de hierro afectan a una de cada tres personas en todo el mundo. Sin embargo, a pesar de las graves consecuencias y su alta prevalencia sigue siendo una afección poco reconocida.
Y es que, el déficit de hierro, con y sin anemia, puede ser debilitante y exacerbar las enfermedades crónicas subyacentes, lo que lleva a una mayor morbilidad y mortalidad. Sus síntomas pueden manifestarse de diferentes maneras, son difíciles de determinar y pueden asociarse con otras condiciones de salud. Los más comunes son la fatiga, la piel pálida, las uñas quebradizas y la incapacidad para concentrarse.
El Día Mundial del Déficit de Hierro 2019 pone de relieve la importancia de esta deficiencia en la salud de las mujeres y su conexión con la insuficiencia cardíaca crónica. Ed Harding, miembro de la Red Europea de Políticas de Insuficiencia Cardíaca, ha señalado que “el déficit de hierro en condiciones como la insuficiencia cardíaca crónica (ICC) es un problema muy grave. En Europa, el 50 por ciento de los pacientes con ICC tienen alguna forma de déficit de hierro. Este día internacional tiene un papel importante para crear conciencia sobre estas afecciones y ayudar a las personas a comprender sus síntomas, buscar un diagnóstico adecuado y, en última instancia, recibir el tratamiento correcto".
Para ofrecer más información a la población, se ha creado la web del Día del Déficit de Hierro, y sus perfiles en Instagram y Twitter, además de los hashtags #TakeIronSeriously y #IDD.
La página web incluye todos los materiales de la campaña y un comprobador de síntomas, que utilizará animaciones para explicar los efectos más comunes del déficit de hierro y la anemia por deficiencia de hierro a fin de educar para que las personas afectadas reconozcan la afección y busquen ayuda. Además, también hay disponibles testimonios de pacientes y enlaces a redes sociales.
Acerca del déficit de hierro
Aunque el déficit de hierro puede afectar a cualquier persona, es más frecuente en mujeres premenopáusicas, mujeres embarazadas y niños menores de cinco años. Si no se trata, puede convertirse en anemia por deficiencia de hierro. Los efectos del déficit de hierro difieren de una persona a otra, pero pueden estar relacionados con una disminución general de la salud y el bienestar general. Incluso sin anemia, la deficiencia de hierro puede ser debilitante, exacerbar una enfermedad crónica subyacente y conducir a una mayor morbilidad y mortalidad. Los síntomas comunes incluyen fatiga, piel pálida, uñas quebradizas, antojos de injerir tierra, arcilla y hielo y la incapacidad para concentrarse. En niños, el déficit de hierro puede afectar significativamente el desarrollo cognitivo y motor.
También te puede interesar








